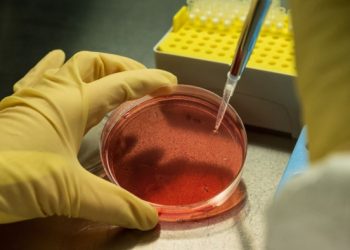
Fund for struggling biotechs takes aim at ‘tragedy’ for shareholders

Want a Fortell Hearing Aid? Well, Who Do You Know?
December 3, 2025
Lars Windhorst’s Tennor Holding declared bankrupt
June 18, 2025
How To Buy And Trade Tokens On The SEI Network
April 19, 2026
Schematik Is ‘Cursor for Hardware.’ Anthropic Wants In
April 19, 2026